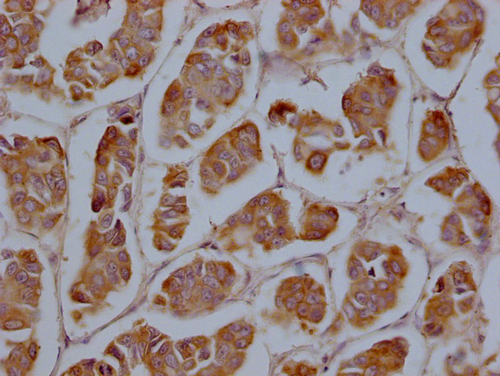

CYP2A13 Antibody
-
中文名稱:CYP2A13兔多克隆抗體
-
貨號:CSB-PA621969LA01HU
-
規格:¥440
-
圖片:
-
Western Blot
Positive WB detected in: A549 whole cell lysate, Mouse liver tissue
All lanes: CYP2A13 antibody at 1:2000
Secondary
Goat polyclonal to rabbit IgG at 1/50000 dilution
Predicted band size: 57 kDa
Observed band size: 57 kDa -
IHC image of CSB-PA621969LA01HU diluted at 1:200 and staining in paraffin-embedded human breast cancer performed on a Leica BondTM system. After dewaxing and hydration, antigen retrieval was mediated by high pressure in a citrate buffer (pH 6.0). Section was blocked with 10% normal goat serum 30min at RT. Then primary antibody (1% BSA) was incubated at 4°C overnight. The primary is detected by a Goat anti-rabbit polymer IgG labeled by HRP and visualized using 0.05% DAB.
-
-
其他:
產品詳情
-
產品名稱:Rabbit anti-Homo sapiens (Human) CYP2A13 Polyclonal antibody
-
Uniprot No.:
-
基因名:CYP2A13
-
別名:Cytochrome P450 2A13 (EC 1.14.14.1) (CYPIIA13), CYP2A13
-
宿主:Rabbit
-
反應種屬:Human, Mouse
-
免疫原:Recombinant Human Cytochrome P450 2A13 protein (252-354aa)
-
免疫原種屬:Homo sapiens (Human)
-
標記方式:Non-conjugated
本頁面中的產品,CYP2A13 Antibody (CSB-PA621969LA01HU),的標記方式是Non-conjugated。對于CYP2A13 Antibody,我們還提供其他標記。見下表:
-
克隆類型:Polyclonal
-
抗體亞型:IgG
-
純化方式:>95%, Protein G purified
-
濃度:It differs from different batches. Please contact us to confirm it.
-
保存緩沖液:Preservative: 0.03% Proclin 300
Constituents: 50% Glycerol, 0.01M PBS, pH 7.4 -
產品提供形式:Liquid
-
應用范圍:ELISA, WB, IHC
-
推薦稀釋比:
Application Recommended Dilution WB 1:1000-1:5000 IHC 1:100-1:500 -
Protocols:
-
儲存條件:Upon receipt, store at -20°C or -80°C. Avoid repeated freeze.
-
貨期:Basically, we can dispatch the products out in 1-3 working days after receiving your orders. Delivery time maybe differs from different purchasing way or location, please kindly consult your local distributors for specific delivery time.
-
用途:For Research Use Only. Not for use in diagnostic or therapeutic procedures.
相關產品
靶點詳情
-
功能:Exhibits a coumarin 7-hydroxylase activity. Active in the metabolic activation of hexamethylphosphoramide, N,N-dimethylaniline, 2'-methoxyacetophenone, N-nitrosomethylphenylamine, and the tobacco-specific carcinogen, 4-(methylnitrosamino)-1-(3-pyridyl)-1-butanone. Possesses phenacetin O-deethylation activity.
-
基因功能參考文獻:
- CYP2A13 is the most efficient enzyme to metabolize N'-Nitrosonornicotine in vitro. PMID: 27567546
- The results of this case-control study suggested that the CYP2A13*1/*2 genotype decreased the risk of susceptibility to bladder cancer in Japanese smokers PMID: 27725446
- CYP2A13 levels in human lungs can be suppressed by disease-associated inflammation in tissue donors. PMID: 25710941
- an etiologically relevant interaction between CYP2A13 and ABCB1 associated with lung cancer was analysed PMID: 25667220
- The transgenic CYP2A13 is active. PMID: 24907355
- CYP2A13 played a critical role in AFB1-induced neoplastic transformation. PMID: 24114584
- Data suggest important role of CYP2A13 in AFG1- (aflatoxin G1)-induced cytotoxicity, DNA damage, and activation of signal pathways in bronchial epithelium; data suggest similarities in CYP2A13-catalyzed bioactivation of AFG1 and AFB1 (aflatoxin B1). PMID: 23907605
- CYP2A13 is efficient in 4-(methylnitrosamino)-1-(3-pyridyl)-1-butanone bioactivation in vivo and it can mediate 4-(methylnitrosamino)-1-(3-pyridyl)-1-butanone-induced lung tumorigenesis. PMID: 23917075
- Findings suggest the potential involvement of pulmonary CYP2A13 in the early occurrence of NSCLC as well as in the development of EGFR gene mutations. PMID: 23752126
- an efficient approach for expressing functionally characterized, highly active and homogeneous CYP2A13 proteins. PMID: 23463547
- CYP2A13 plays an important role in low-concentration AFB1-induced DNA damage, possibly linking environmental airborne AFB1 to genetic injury in the human respiratory system. PMID: 23583631
- Findings suggest that CYP2A13 plays an important role in low-concentration AFB1-induced DNA damage, possibly linking environmental airborne AFB1 to genetic injury in human respiratory system. PMID: 23602888
- The differential distribution pattern of CYP2A13 in the respiratory tract, which is of importance in considering the pulmonary susceptibility to carcinogens and the following lung cancer development, is detailed. PMID: 22890016
- Tissue distribution of transgenic mRNA expression agrees well with the known respiratory tract-selective expression of CYP2A13 and CYP2F1 and hepatic expression of CYP2B6 in humans. PMID: 22397853
- Report selective expression of CYP2A13 in human pancreatic alpha-islet cells. PMID: 22798551
- Although both the hepatic CYP2A6 and respiratory CYP2A13 enzymes metabolize these compounds, CYP2A13 does so with much higher catalytic efficiency, but the structural basis for this has been unclear PMID: 22700965
- The distribution frequencies of all eight known CYP2A13 missense alleles were examined in a Chinese Han population. PMID: 22315333
- present results provide the first direct in vitro evidence demonstrating the predominant roles of CYP2A13 in 4-(methylnitrosamino)-1-(3-pyridyl)-1-butanone (NNK)-induced mutagenesis, possibly via metabolic activation of NNK alpha-hydroxylation PMID: 21473878
- single nucleotide polymorphisms within the CYP2A13 gene affect metabolism of 5-methoxypsoralen in humans. PMID: 20798279
- 2 novel polymorphisms T478C and T494C in CYP2A13 gene were associated with significantly reduced risk of cancer. CYP2A13 haplotype carrying variant alleles of T478C/T494C found associated with reduced risk of head/neck cancer. PMID: 20534012
- significant interaction between smoking and methylation status of CYP2A13 in head and neck cancer. PMID: 20846153
- The mechanisms underlying the decreased allelic expression of a common CYP2A13 allele (7520C>G) in the human lung, were investigated. PMID: 20431511
- Observed clear prevalence of the variant CYP2A13 alelle causing premature stop at codon 101 (knockout allele *7) among the controls in comparison with the pancreatic cancer patients. PMID: 19812523
- genetic polymorphism: identification of single-nucleotide polymorphisms and functional characterization of an Arg257Cys variant PMID: 12130698
- CYP2A13 allele is associated with reduced risk of lung adenocarcinoma, suggesting the role of NNK-CYP2A13 interaction as a causative factor for the cancer. PMID: 14633739
- In order to investigate the extent of CYP2A13 genetic polymorphism in a French Caucasian population of 102 individuals, a screening for sequence variations in the 5'-untranslated and protein encoding regions of its gene was performed. PMID: 15063809
- The CYP2A13 Arg257Cys variant represents a common polymorphism in Chinese, with the 257Cys allele frequency being similar to the Hispanic and Asian groups, but significantly lower than in blacks PMID: 15115698
- CYP2A13 mutant proteins showed a significant decrease in the catalytic efficiency for NNK alpha-hydroxylation PMID: 15333516
- structure of CYP2A13 was determined to 2.35A by x-ray crystallography and compared with structures of CYP2A6. PMID: 17428784
- the reported association of the CYP2A13(*)2 allele with decreased incidences of lung adenocarcinoma in smokers can be at least partly explained by a decrease in CYP2A13 function PMID: 18669584
顯示更多
收起更多
-
亞細胞定位:Endoplasmic reticulum membrane; Peripheral membrane protein. Microsome membrane; Peripheral membrane protein.
-
蛋白家族:Cytochrome P450 family
-
組織特異性:Expressed in liver and a number of extrahepatic tissues, including nasal mucosa, lung, trachea, brain, mammary gland, prostate, testis, and uterus, but not in heart, kidney, bone marrow, colon, small intestine, spleen, stomach, thymus, or skeletal muscle.
-
數據庫鏈接:
Most popular with customers
-
-
YWHAB Recombinant Monoclonal Antibody
Applications: ELISA, WB, IHC, IF, FC
Species Reactivity: Human, Mouse, Rat
-
Phospho-YAP1 (S127) Recombinant Monoclonal Antibody
Applications: ELISA, WB, IHC
Species Reactivity: Human
-
-
-
-
-